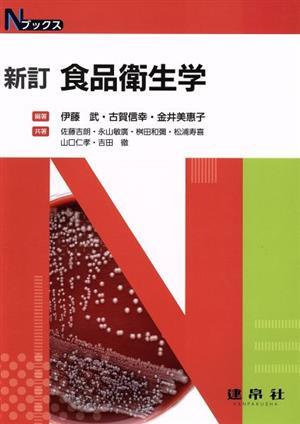
...

食品衛生学 新訂 Nブックス/伊藤武(編著),古賀信幸(編著),金井美惠子(編著) 收藏
一口价: 1210 (合 58.32 人民币)
拍卖号:1155575968
开始时间:11/22/2025 05:06:06
个 数:1
结束时间:11/29/2025 04:06:06
商品成色:二手
可否退货:不可
提前结束:不可
日本邮费:买家承担
自动延长:不可
最高出价:
出价次数:0

伊藤武(編著),古賀信幸(編著),金井美惠子(編著)
伊藤武(編著),古賀信幸(編著),金井美惠子(編著)




| 出价者 | 信用 | 价格 | 时间 |
|---|
推荐